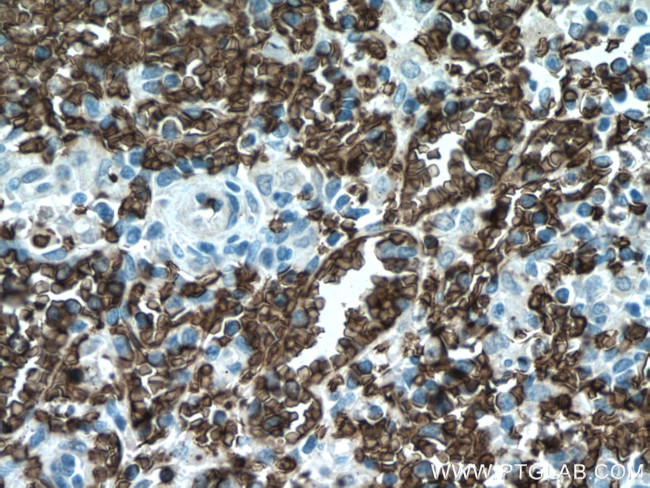
SLC4A1 Antibody in Immunohistochemistry (Paraffin) (IHC (P))

Search
Proteintech
SLC4A1 Polyclonal Antibody
{{$productOrderCtrl.translations['antibody.pdp.commerceCard.promotion.promotions']}}
{{$productOrderCtrl.translations['antibody.pdp.commerceCard.promotion.viewpromo']}}
{{$productOrderCtrl.translations['antibody.pdp.commerceCard.promotion.promocode']}}: {{promo.promoCode}} {{promo.promoTitle}} {{promo.promoDescription}}. {{$productOrderCtrl.translations['antibody.pdp.commerceCard.promotion.learnmore']}}
产品信息
28131-1-AP
种属反应
宿主/亚型
分类
类型
抗原
偶联物
形式
浓度
规格
纯化类型
保存液
内含物
保存条件
运输条件
产品详细信息
Immunogen sequence: MEELQDDYE DMMEENLEQE EYEDPDIPES QMEEPAAHDT EATATDYHTT SHPGTHKVYV ELQELVMDEK NQELRWMEAA RWVQLEENLG ENGAWGRPHL SHLTFWSLLE LRRVFTKGTV LLDLQETSLA GVANQLLDRF IFEDQIRPQD REELLRALLL KHSHAGELEA LGGVKPAVLT RSGDPSQPLL PQHSSLETQL F (1-200 aa encoded by BC101570 )
靶标信息
The Band 3 protein is the most abundant integral protein of human erythrocyte membranes and functions as the major anion transporter polypeptide of erythrocytes. Band 3 is a 90-100 kDa protein, its microheterogeneity is ascribed mainly to the structural heterogeneity of the carbohydrate moiety. The C-terminal portion of the molecule spans the membrane several times, and is responsible for anion transport. The N-terminal portion, comprising almost half of the polypeptide chain of Band 3, is located inside the red cell and interacts with cytoskeletal and cytoplasmic proteins such as ankyrin.
仅用于科研。不用于诊断过程。未经明确授权不得转售。
生物信息学
蛋白别名: AE 1; Anion exchange protein 1; anion exchanger 1; anion exchanger-1; band 3 anion exchanger; Band 3 anion transport protein; CAMP; CD233; Diego blood group; erythrocyte membrane protein band 3; erythroid anion exchange protein; Froese blood group; MEB3; MGC116750; MGC116753; MGC126619; MGC126623; solute carrier family 4 (anion exchanger), member 1 (Diego blood group); Solute carrier family 4 member 1; solute carrier family 4, anion exchanger, member 1 (erythrocyte membrane protein band 3, Diego blood group); solute carrier family 4, anion exchanger, number 1; Swann blood group; UNIMAS band 3; AE1; unnamed protein product; Waldner blood group; Wright blood group; ZNF828
基因别名: AE1; BND3; CD233; CHC; DI; EMPB3; EPB3; FR; l11Jus51; RTA1A; SAO; SLC4A1; SPH4; SW; WD; WD1; WR
UniProt ID: (Human) P02730, (Mouse) P04919
Entrez Gene ID: (Human) 6521, (Mouse) 20533